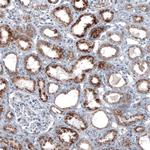
PMP70 Antibody in Immunohistochemistry (Paraffin) (IHC (P))

Search
Invitrogen
PMP70 Monoclonal Antibody (CL2524)
{{$productOrderCtrl.translations['antibody.pdp.commerceCard.promotion.promotions']}}
{{$productOrderCtrl.translations['antibody.pdp.commerceCard.promotion.viewpromo']}}
{{$productOrderCtrl.translations['antibody.pdp.commerceCard.promotion.promocode']}}: {{promo.promoCode}} {{promo.promoTitle}} {{promo.promoDescription}}. {{$productOrderCtrl.translations['antibody.pdp.commerceCard.promotion.learnmore']}}
图: 1 / 12
PMP70 Antibody (MA5-31368) in ICC/IF

产品信息
MA5-31368
种属反应
已发表种属
宿主/亚型
分类
类型
克隆号
偶联物
形式
浓度
规格
纯化类型
保存液
内含物
保存条件
运输条件
RRID
产品详细信息
Immunogen sequence: MVSQQEKGIE GVQVIPLIPG AGEIIIADNI IKFDHVPLAT PNGDVLIRDL NFEVRSGANV LICGP
Highest antigen sequence indentity to the following orthologs: Mouse - 86%, Rat - 87%.
靶标信息
Peroxisomes are single membrane organelles which are involved with many important biochemical pathways and are found in almost all eukaryotic cells. Various toxins including, phenols, alcohols, and aldehydes are targeted for modification by peroxisomes. Long chain fatty acid metabolism via beta-oxidation is also mediated by this organelle. Loss of peroxisomal functions may result in diseases such as Zellweger syndrome, hyperpipecolic acidemia, neonatal adrenoleukodystrophy, and infantile Refsum" disease. Peroxisomal membrane protein 70 (PMP70) is an abundant, integral membrane protein of the peroxisome. This protein is induced by treatment with hypolipidemic agents in parallel with peroxisome proliferation and stimulation of the peroxisomal beta-oxidation enzymes.
仅用于科研。不用于诊断过程。未经明确授权不得转售。
生物信息学
蛋白别名: 70 kDa peroxisomal membrane protein; ATP-binding cassette sub-family D member 3; ATP-binding cassette, sub-family D (ALD), member 3; dJ824O18.1 (ATP-binding cassette, sub-family D (ALD), member 3 (PMP70, PXMP1)); peroxisomal membrane protein 1 (70kD, Zellweger syndrome); peroxisomal membrane protein 70 kDa; Peroxisomal membrane protein-1 (70kD); PMP70; unnamed protein product
基因别名: ABC43; ABCD3; CBAS5; PMP70; PXMP1; ZWS2
UniProt ID: (Human) P28288
Entrez Gene ID: (Human) 5825




